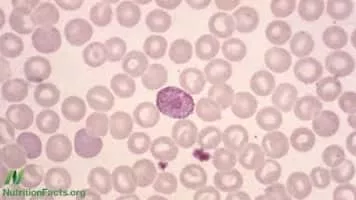

Count Blood Count
| Use attributes for filter ! | |
| First appearance | Transylvania 6-5000 |
|---|---|
| Species | Vampire |
| Voices | Ben Frommer |
| Frank Welker | |
| Corey Burton | |
| Joe Alaskey | |
| Jeff Bennett | |
| Date of Reg. | |
| Date of Upd. | |
| ID | 919279 |
About Count Blood Count
Count Blood Count is a vampire from the Warner Brothers Looney Tunes animated shorts. His appearance recalls that of Lon Chaney's vampire character The Man in the Beaver Hat from London After Midnight, the first Hollywood-produced vampire film.